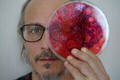
Ross Goldstein

Ross Goldstein - Eigth House (LP)
1. Ross Goldstein
2. Ross Goldstein
3. Ross Goldstein
4. Ross Goldstein
5. Ross Goldstein
6. Ross Goldstein
7. Ross Goldstein
8. Ross Goldstein
τύπος
LP δίσκος
Είδος
Υποείδος
Έτος έκδοσης
Ημερομηνία κυκλοφορίας
01.11.2018
Εκδοτικός οίκος
Έγγραφα
Οδηγίες χρήσης
Οδηγίες ασφαλείας
Συμβουλέψου το εγχειρίδιο χρήσης για τις ειδικές οδηγίες ασφαλείας για αυτό το προϊόν.